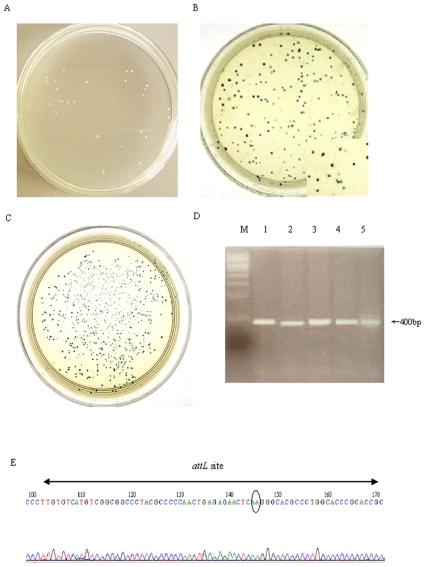

对噬菌体 phiC31 整合酶中高度保守残基的突变分析揭示了 DNA 重组所必需的关键氨基酸。
Mutational analysis of highly conserved residues in the phage phiC31 integrase reveals key amino acids necessary for the DNA recombination.
机构信息
State Key Laboratory of Genetic Engineering, Institute of Genetics, School of Life Sciences, Fudan University, Shanghai, China.
出版信息
PLoS One. 2010 Jan 25;5(1):e8863. doi: 10.1371/journal.pone.0008863.
BACKGROUND
Amino acid sequence alignment of phage phiC31 integrase with the serine recombinases family revealed highly conserved regions outside the catalytic domain. Until now, no system mutational or biochemical studies have been carried out to assess the roles of these conserved residues in the recombination of phiC31 integrase.
METHODOLOGY/PRINCIPAL FINDINGS: To determine the functional roles of these conserved residues, a series of conserved residues were targeted by site-directed mutagenesis. Out of the 17 mutants, 11 mutants showed impaired or no recombination ability, as analyzed by recombination assay both in vivo and in vitro. Results of DNA binding activity assays showed that mutants (R18A, I141A, L143A,E153A, I432A and V571A) exhibited a great decrease in DNA binding affinity, and mutants (G182A/F183A, C374A, C376A/G377A, Y393A and V566A) had completely lost their ability to bind to the specific target DNA attB as compared with wild-type protein. Further analysis of mutants (R18A, I141A, L143A and E153A) synapse and cleavage showed that these mutants were blocked in recombination at the stage of strand cleavage.
CONCLUSIONS/SIGNIFICANCE: This data reveals that some of the highly conserved residues both in the N-terminus and C-terminus region of phiC31 integrase, play vital roles in the substrate binding and cleavage. The cysteine-rich motif and the C-tail val-rich region of phiC31 integrase may represent the major DNA binding domains of phiC31 integrase.
背景
噬菌体 phiC31 整合酶与丝氨酸重组酶家族的氨基酸序列比对显示,催化结构域外存在高度保守区域。到目前为止,尚未进行系统的突变或生化研究来评估这些保守残基在 phiC31 整合酶重组中的作用。
方法/主要发现:为了确定这些保守残基的功能作用,通过定点突变靶向一系列保守残基。在 17 个突变体中,有 11 个突变体显示出重组能力受损或丧失,这是通过体内和体外重组分析得出的。DNA 结合活性分析结果表明,突变体(R18A、I141A、L143A、E153A、I432A 和 V571A)的 DNA 结合亲和力显著降低,而突变体(G182A/F183A、C374A、C376A/G377A、Y393A 和 V566A)与野生型蛋白相比,完全丧失了与特定靶 DNA attB 结合的能力。对突变体(R18A、I141A、L143A 和 E153A)的突触和切割进行进一步分析表明,这些突变体在链切割阶段被重组阻断。
结论/意义:这些数据表明,phiC31 整合酶的 N 端和 C 端区域的一些高度保守残基在底物结合和切割中发挥着重要作用。phiC31 整合酶富含半胱氨酸的基序和富含 C 端缬氨酸的区域可能代表 phiC31 整合酶的主要 DNA 结合结构域。